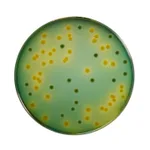

Himedia Alkaline Saline Peptone Water (ASPW)
상품 한눈에 보기
Vibrio 종 검출을 위한 농축 배지로, 식품 및 수질 시료 분석에 적합함. ISO 기준에 따른 검사용으로 V. parahaemolyticus와 V. cholerae 검출에 사용. 식품, 사료, 환경 시료 등 다양한 분야에 적용 가능.
브랜드: Himedia
✨AI 추천 연관 상품
AI가 분석한 이 상품과 연관된 추천 상품들을 확인해보세요
연관 상품을 찾고 있습니다...
Alkaline Saline Peptone Water (ASPW)
Alkaline Saline Peptone Water (ASPW)는 ISO 기준에 따라 식품 및 수질 시료로부터 Vibrio 종을 농축 배양하는 데 사용되는 배지입니다.
이 배지는 사람의 장 질환을 유발하는 주요 병원성 Vibrio 종인 V. parahaemolyticus와 V. cholerae 검출을 위한 표준화된 수평적 검사 방법에 적합합니다.
또한, 식품, 사료, 환경 시료 등 다양한 분야에서 활용 가능합니다.
제품 사양
| 항목 | 내용 |
|---|---|
| Product Name | Alkaline Saline Peptone Water (ASPW) |
| SKU | M1887 |
| Customized Product Available | No |
🏷️Himedia 상품 둘러보기
동일 브랜드의 다른 상품들을 확인해보세요
배송/결제/교환/반품 안내
배송 정보
| 기본 배송비 |
| 교환/반품 배송비 |
|
|---|---|---|---|
| 착불 배송비 |
| ||
| 교환/반품 배송비 |
| ||
결제 및 환불 안내
| 결제수단 |
|
|---|---|
| 취소 |
|
| 반품 |
|
| 환급 |
|
교환 및 반품 접수
| 교환 및 반품 접수 기한 |
|
|---|---|
| 교환 및 반품 접수가 가능한 경우 |
|
| 교환 및 반품 접수가 불가능한 경우 |
|
교환 및 반품 신청
| 교환 절차 |
|
|---|---|
| 반품 절차 |
|
문의 0
로그인 후 문의를 할 수 있습니다.